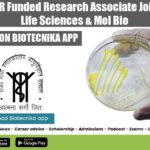
SGPGIMS ICMR Funded Research Associate Job For Biotech, Life Sciences & Mol Bio SGPGIMS Research Opening 2022

Home Search
biology - search results
If you're not happy with the results, please do another search
Homi Bhabha Cancer Hospital JRF Post With Up to Rs. 54,000 pm Pay –...
ACTREC Vacancy JRF 2022 For Life Sciences, Attend Walk-In
ACTREC Vacancy JRF 2022 For Life Sciences, Attend Walk-In. MSc Life Sciences can walk-in for a...
NIPER MSc & MTech Biotech, Life Sciences, Bioinformatics JRF Recruitment
NIPER Ahmedabad Research Fellow Job For MSc & MTech
NIPER Ahmedabad Research Fellow Job For MSc & MTech. National Institute of Pharmaceutical Education & Research,...
CSIR-IMTECH Project Jobs For Life Sciences – Apply Online
CSIR-IMTECH Project Jobs For Life Sciences - Apply Online
CSIR-IMTECH Project Jobs For Life Sciences - Apply Online. Project Associate Recruitment. Interested and eligible applicants...
IIT Kharagpur MTech, BTech & MSc Biotech Research Fellowship
Research Fellowship IIT Kharagpur For Biotech, Life Sciences - Apply Online
Research Fellowship IIT Kharagpur For Biotech, Life Sciences - Apply Online. MTech Biotechnology is...
NIANP SRF Job Opening For Life Sciences Candidates, Applications Invited
NIANP SRF Job Opening For Life Sciences Candidates, Applications Invited
NIANP SRF Job Opening For Life Sciences Candidates, Applications Invited. Bengaluru jobs. NIANP Bengaluru vacancies....
Biotecnika Times Newsletter 05.08.2022 NCBS Latest Recruitment, Tocklai Life Sciences
Biotecnika Times - NCBS Latest Recruitment, Tocklai Life Sciences
Govt NDDB Genomics Project Executive With Rs. 43,200 pm Pay, Apply Online
Govt NDDB Project Vacancy For...
SGPGIMS ICMR Funded Research Associate Job For Biotech, Life Sciences & Mol Bio
SGPGIMS Research Opening 2022 For PhD Life Sciences, Applications Invited
SGPGIMS Research Opening 2022 For PhD Life Sciences, Applications Invited. SGPGIMS is recruiting candidates for...
ICGEB Research Associate Job For Bioinformatics, Life Sciences, Biotech
ICGEB Associate Vacancy 2022 For PhD - Biotech, Life Sciences Apply
ICGEB Associate Vacancy 2022 For PhD - Biotech, Life Sciences Apply. PhD Biotechnology/ Bioinformatics/...
RCB Faridabad Project Assistant Job For BSc & MSc Life Sciences, Biotech
RCB BSc MSc Jobs For Biotech, Life Sciences - Apply Online
RCB BSc MSc Jobs For Biotech, Life Sciences - Apply Online. MSc & BSc...
Presidency University MSc & MTech JRF Job Opening, Attend Walk-In
Presidency University JRF 2022 For MSc & MTech Biotech, Life Sciences
Presidency University JRF 2022 For MSc & MTech Biotech, Life Sciences. Junior Research Fellow...
Biotecnika Times Newsletter 04.08.2022 Govt NDDB Recruitment, Govt MoEF&CC ZSI
Biotecnika Times - Govt NDDB Recruitment, Govt MoEF&CC ZSI
Govt NDDB Junior Analyst Job For Life Sciences, Apply Online
Govt NDDB Analyst Vacancy For MSc Life...
Govt NDDB Junior Analyst Job For Life Sciences, Apply Online
Govt NDDB Analyst Vacancy For MSc Life Sciences - Apply Online
Govt NDDB Analyst Vacancy For MSc Life Sciences - Apply Online. Junior Analyst Vacancy...
NIMHANS MSc & BTech Project Assistant Job For Life Sciences, Biotech
NIMHANS Project Vacancy 2022 For MSc & BTech Life Sciences
NIMHANS Project Vacancy 2022 For MSc & BTech Life Sciences. MSc life sciences vacancy. BTech...
Govt MoEF&CC ZSI Life & Biological Sciences Project Tech Officer Jobs – Applications Invited
ZSI Project Tech Jobs For Biological & Life Sciences, Applications Invited
ZSI Project Tech Jobs For Biological & Life Sciences, Applications Invited. MSc Zoology, Life...
AIIMS Delhi MSc Life Sciences JRF Job Opening, Applications Invited
AIIMS Delhi Vacancy JRF For MSc Life Sciences, Applications Invited
AIIMS Delhi Vacancy JRF For MSc Life Sciences, Applications Invited. MSc in life science can...